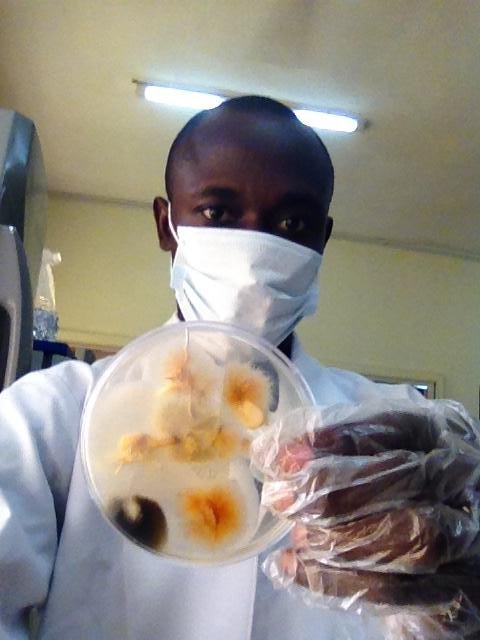
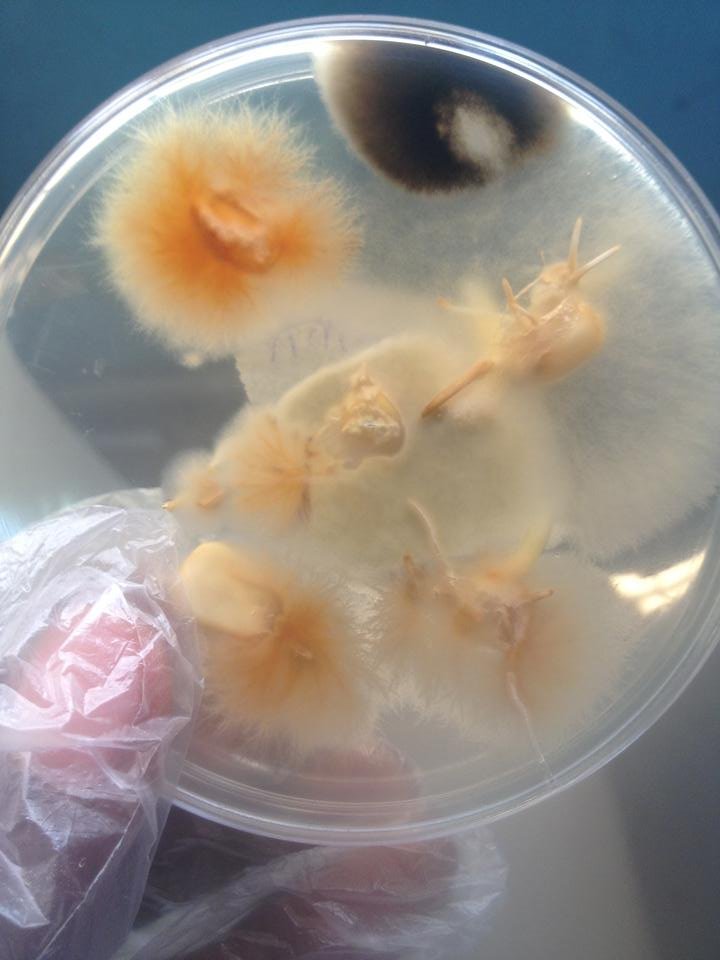

Thank God it's Friday!!! TGIF
I honestly realize now that my cravings for weekends has suddenly sky rocketed.
Ever since I began my masters project work my life,my time, my space, my rest, my flex, my peace seems stolen . My colleague and and I started on Monday;plating, preparing agars, inoculating and culturing etc. I mean OMG! It's been stress all through as in I get back home late ,eat late, sleep anyhow, wake up somehow and hurry again to school I.e university of Abuja to continue working. Alas! fungi has started growing and as good as that sounds for me it means 'more work '
After today's inoculation I must at least get half of my life back.
Below are pictures of me trying to subculture and sundry work loadssss....
Hmmm I am "simply " researching on the prevalence of Aflatoxin producing aspergillus flavus and it's aflatoxin load in stored maize seeds found in Abuja and Niger state Nigeria.
TG I CAN'T WAIT!!!!

Well done brother! I was wondering why you choose the Abuja and Niger State only.
Wow thanks a million bro....middle belt region is my target and this two states are in the middle belt